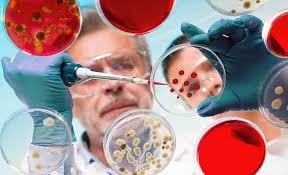

Kansere En Dayanıklı Kan Gurubu Belli Oldu..! İşte O kan grubu
Kanser karşı en dirençli kan gurubu hangisi merak ediyor musunuz ?Belkide sizin kan grubunuz kansere en dayanıklı kan grubu işte o kan grubu

En Dayanıklı Kan Gurubu
İsveç’te bilim insanları tarafından yapılan yeni bir çalışma, 0 (sıfır) kan gurubuna sahip bireylerin kansere karşı daha korunaklı olduğunu ortaya koydu.
İsveç’te bilim insanları tarafından yapılan yeni bir çalışma, 0 (sıfır) kan gurubuna sahip bireylerin kansere karşı daha korunaklı olduğunu ortaya koydu.İsveç’in Karolinska Enstitüsü’nden bilim insanları yaptıkları araştırmalar sonucunda, kişinin kan grubu ile kanser geliştirme olasılığı arasında bağlantı olduğu belirlendi.
A KAN GRUBUNUN MİDE KANSERİNE YAKALANMA RİSKİ DAHA FAZLA Araştırma kapsamında 35 yıl boyunca muayene edilen bir milyondan fazla insanın verileri değerlendirildi. Araştırmacılar, A kan grubuna sahip kişilerin mide kanserine yakalanma riskinin daha fazla olduğunu tespit etti.Kanserden korunmanın 13 yolu
 Bilim insanlarının tedavisi için üzerinde çalıştığı kanser hastalığı, günümüzün en önemli sağlık sorunlarının başında geliyor. Dünyada her yıl 18,1 milyon kişiye kanser tanısı konarken, 9,6 milyon kişi de kanser nedeniyle yaşamını yitiriyor. Türkiye’de ise her yıl 170 bin kişinin kansere yakalandığını ve yaklaşık 150 bin kişinin hayatını kaybettiğini belirten Anadolu Sağlık Merkezi Onkolojik Bilimler Koordinatörü, Medikal Onkoloji Uzmanı Prof. Dr. Necdet Üskent, “Türkiye’de erkeklerde akciğer, prostat, kolon ve mide kanseri daha sık görülürken, kadınlarda meme, tiroid, kolon ve mide kanserleri daha sık görülüyor. Dünyada ise sırası ile en fazla görülen kanserler akciğer, meme, prostat ve kolo-rektal kanserler. En fazla ölüme neden olanlar ise sırasıyla akciğer, kolo-rektal, mide ve karaciğer kanserleri” dedi. Prof. Dr. Necdet Üskent, kanserden korunma yolları ile ilgili bilgiler verdi.
Bilim insanlarının tedavisi için üzerinde çalıştığı kanser hastalığı, günümüzün en önemli sağlık sorunlarının başında geliyor. Dünyada her yıl 18,1 milyon kişiye kanser tanısı konarken, 9,6 milyon kişi de kanser nedeniyle yaşamını yitiriyor. Türkiye’de ise her yıl 170 bin kişinin kansere yakalandığını ve yaklaşık 150 bin kişinin hayatını kaybettiğini belirten Anadolu Sağlık Merkezi Onkolojik Bilimler Koordinatörü, Medikal Onkoloji Uzmanı Prof. Dr. Necdet Üskent, “Türkiye’de erkeklerde akciğer, prostat, kolon ve mide kanseri daha sık görülürken, kadınlarda meme, tiroid, kolon ve mide kanserleri daha sık görülüyor. Dünyada ise sırası ile en fazla görülen kanserler akciğer, meme, prostat ve kolo-rektal kanserler. En fazla ölüme neden olanlar ise sırasıyla akciğer, kolo-rektal, mide ve karaciğer kanserleri” dedi. Prof. Dr. Necdet Üskent, kanserden korunma yolları ile ilgili bilgiler verdi.Sigardan uzak durulmalı
Sigara içerisinde 4000’in üzerinde zararlı kimyasal bulunuyor. Bu kimyasallar DNA’ya zarar vererek önemli genlerde değişikliğe neden oluyor. Kanser hücreleri vücutta gelişerek hızla ve kontrol dışı çoğalarak kansere neden oluyor. Akciğer, yumurtalık kanserleri, bazı lösemi türleri, ağız, gırtlak, üst yutak, burun ve sinüsler, yemek borusu, karaciğer, pankreas, mide, böbrek, mesane, rahim ve bağırsak kanserleri doğrudan sigara kullanımı ile ilgili.
Şeker doğal yiyeceklerden karşılanmalı
Vücutta kanser hücreleri dahil, tüm hücrelerin şekere ihtiyacı var. Şekerin neden olduğu aşırı kilolar, bel çevresindeki yağlanma ve obezite de kanseri tetikleyen en önemli faktörler arasında. Şeker sebze ve meyvelerden karşılanmalı. Çocuklara küçük yaşlardan itibaren sağlıklı beslenme alışkanlığı kazandırılmalı, sağlıklı atıştırmalıklar özendirilmeli. Fazla yağlı ve şekerli gıdaların tüketilmesinin kanserle ilişkili olduğu kanıtlanmış. Şekerli gıdalar vücutta enflamasyonu da (iltihap) artıyor. Kanserin kökeni olan enflamasyon, kanser hücrelerinin çoğalmasına da neden oluyor.Yağlı yiyeceklerden uzak durulmalı
 Kızarmış yiyecekler, yağlı etler ve diğer yüksek yağ oranlı yiyecekler daha az tüketilmeli. Günde en az 5 tane meyve ve sebze yenmeli, özellikle yeşil yapraklı ve yüksek C vitaminli besinler, turunçgiller tüketilmeli. Yulaf gibi tahıllar ve haftada 2 kez balık tüketilmeli. Ayrıca ailesinde kanser vakaları olanlar beslenmesine dikkat etmenin yanı sıra düzenli taramalarını da ihmal etmemeli.
Kızarmış yiyecekler, yağlı etler ve diğer yüksek yağ oranlı yiyecekler daha az tüketilmeli. Günde en az 5 tane meyve ve sebze yenmeli, özellikle yeşil yapraklı ve yüksek C vitaminli besinler, turunçgiller tüketilmeli. Yulaf gibi tahıllar ve haftada 2 kez balık tüketilmeli. Ayrıca ailesinde kanser vakaları olanlar beslenmesine dikkat etmenin yanı sıra düzenli taramalarını da ihmal etmemeli.Hareketli yaşam tarzı benimsenmeli
Egzersiz kanser, diyabet, tansiyon, kalp hastalıkları gibi hastalıkların görülme riskini azaltıyor. Düzenli egzersiz metabolizmayı olumlu etkileyerek, bağışıklık sistemini güçlendirerek, fazla kiloları yok ederek ve stresi azaltarak kanser riskini azaltıyor. Metabolik sorunlar, bağışıklık sisteminin zayıflaması ve fazla kilolar da kansere yol açan başlıca nedenler arasında. Çağımızın çocukları çok hareketsiz, parklarda bahçelerde oynamak yerine, televizyon, bilgisayar ya da tablet karşısında oturuyorlar. Haftada 5 gün 30 dakika yürümeyle kolon kanseri ve meme kanseri riski yüzde 30-40 oranında azaltılabiliyor.Sebze ve meyveler iyi yıkanmalı.Sebze ve meyveleri iyi yıkamak, tuzlu ve sirkeli suda bekletmek yiyeceklerin kimyasallarını/ilaçlarının arındırılmasında oldukça önemli.
Elektronik cihazlar
Dünya Sağlık Örgütü’nün yaptığı, 14 ülkeden 31 bilim insanının katıldığı kapsamlı araştırmaya göre cep telefonu beyin kanseri riskini artırıyor. Araştırmada bir beyin kanseri tümörü olan gliomanın oluşum riski, kablosuz sistem kullanımıyla artarken, cep telefonu kullanılırken mutlaka kulaklık kullanılması önerilerek telefonun yastığın altına ya da başucuna konarak uyunmaması gerektiği belirtiliyor.Stresten uzak durulmalı
 Birçok kanser türü, bağırsak hastalıkları, tansiyon, diyabet ve kalp hastalıklarının strese bağlı olduğu bilimsel olarak da kanıtlamış durumda. Kanserden ve diğer hastalıklardan korunmak için stresle mücadeleyi ve stresi biraz daha hafif yaşamayı öğrenmek önemli. Fiziksel aktivite, egzersiz, meditasyon, yoga, müzik terapisi gibi yöntemlerden faydalanılarak stres azaltılabilir.
Birçok kanser türü, bağırsak hastalıkları, tansiyon, diyabet ve kalp hastalıklarının strese bağlı olduğu bilimsel olarak da kanıtlamış durumda. Kanserden ve diğer hastalıklardan korunmak için stresle mücadeleyi ve stresi biraz daha hafif yaşamayı öğrenmek önemli. Fiziksel aktivite, egzersiz, meditasyon, yoga, müzik terapisi gibi yöntemlerden faydalanılarak stres azaltılabilir.Obeziteye karşı önlem alınmalı
Fazla kilolu ve obez kişilerde özellikle menopoz sonrası meme kanseri, bağırsak kanseri, rahim kanseri, yumurtalık kanseri, yemek borusu kanseri, pankreas kanseri, böbrek kanseri, prostat kanseri, mide kanseri ve safra kesesi kanseri riskinin arttığı görülüyor. Araştırmalar fazla kilo ve obezitenin kanseri tetiklediğini gösteriyor. Östrojen ve insülin de dahil olmak üzere, bu hormonların bazılarının yüksek düzeyde olması belirli kanserlere yakalanma riskini arttırabiliyor. Araştırmalar, obezite ve fiziksel aktivite yetersizliğinin yüzde 20-25 oranında özellikle meme, kolon ve yemek borusu kanserlerine yakalanma riskini artırdığını gösteriyor. Obezite ayrıca karaciğer ve rahim kanseri riskini de yüzde 20-30 oranında artırıyor.
Kaliteli uyku uyunmalı
Düzensiz ve kalitesiz uykunun hormonlar ve metabolizmayı olumsuz etkiliyor. Uyku sırasında vücut için fayda sağlayan birçok hormon salgılanıyor. Uyku bozuklukları hem fiziksel hem de ruhsal pek çok hastalığı tetiklediği gibi kanser riskini de artırabiliyor.
Mikrodalga fırınlarda kullanılan kaplara dikkat edilmeli
Mikrodalgaların, yiyeceklerin yapısını bozduğu ve yiyeceklerdeki besin değerlerini oldukça azalttığı iddia ediliyor. Böylece vücuda alınan vitaminlerin değeri bozuk veya değişmiş oluyor. Bu da zamanla kansere yol açabiliyor. Mikrodalga fırını kullanırken kullanılan kapların mikrodalgaya uygun olmasına özellikle dikkat edilmeli.
11:00-16:00 saatleri arasında güneşe çıkılmamalı
Güneş, cilt kanseri riskini artırıyor. Özellikle de güneş ışınlarının, çok yoğun ve kanserojen etkiye sahip oldukları 11:00-16:00 saatlerinde güneşe çıkmamakta yarar var. Cilt tipine uygun, yüksek koruma faktörlü güneş kremlerini kullanmak önemli.
Eskimiş tavalar kullanılmamalı
Eskimiş, çizilmiş teflon tavaların kullanılmamasında fayda var. Ancak kaliteli, yüksek standartlarda üretilmiş tavalarda risk olmadığı belirtiliyor.
Cam ya da ahşap mutfak malzemeleri tercih edilmeli
Plastik, kanserojen maddeler içerir. Bunun yerine cam ya da tahta ürünler kullanılmalı. Ancak artık çok kaliteli plastik ürünler var ve bunlar fırına hatta mikrodalgaya bile girebiliyor.
Reklamlar
01 Kasım 2025
Reklamlar
Bunları da İzleyebilirsiniz
 El ve ayak şişlikleri
El ve ayak şişlikleri  Bu Üç Besini Eksik Etmeyin
Bu Üç Besini Eksik Etmeyin  tarifeli tüm seferlerin iptal edildığı açıklandı.
tarifeli tüm seferlerin iptal edildığı açıklandı.